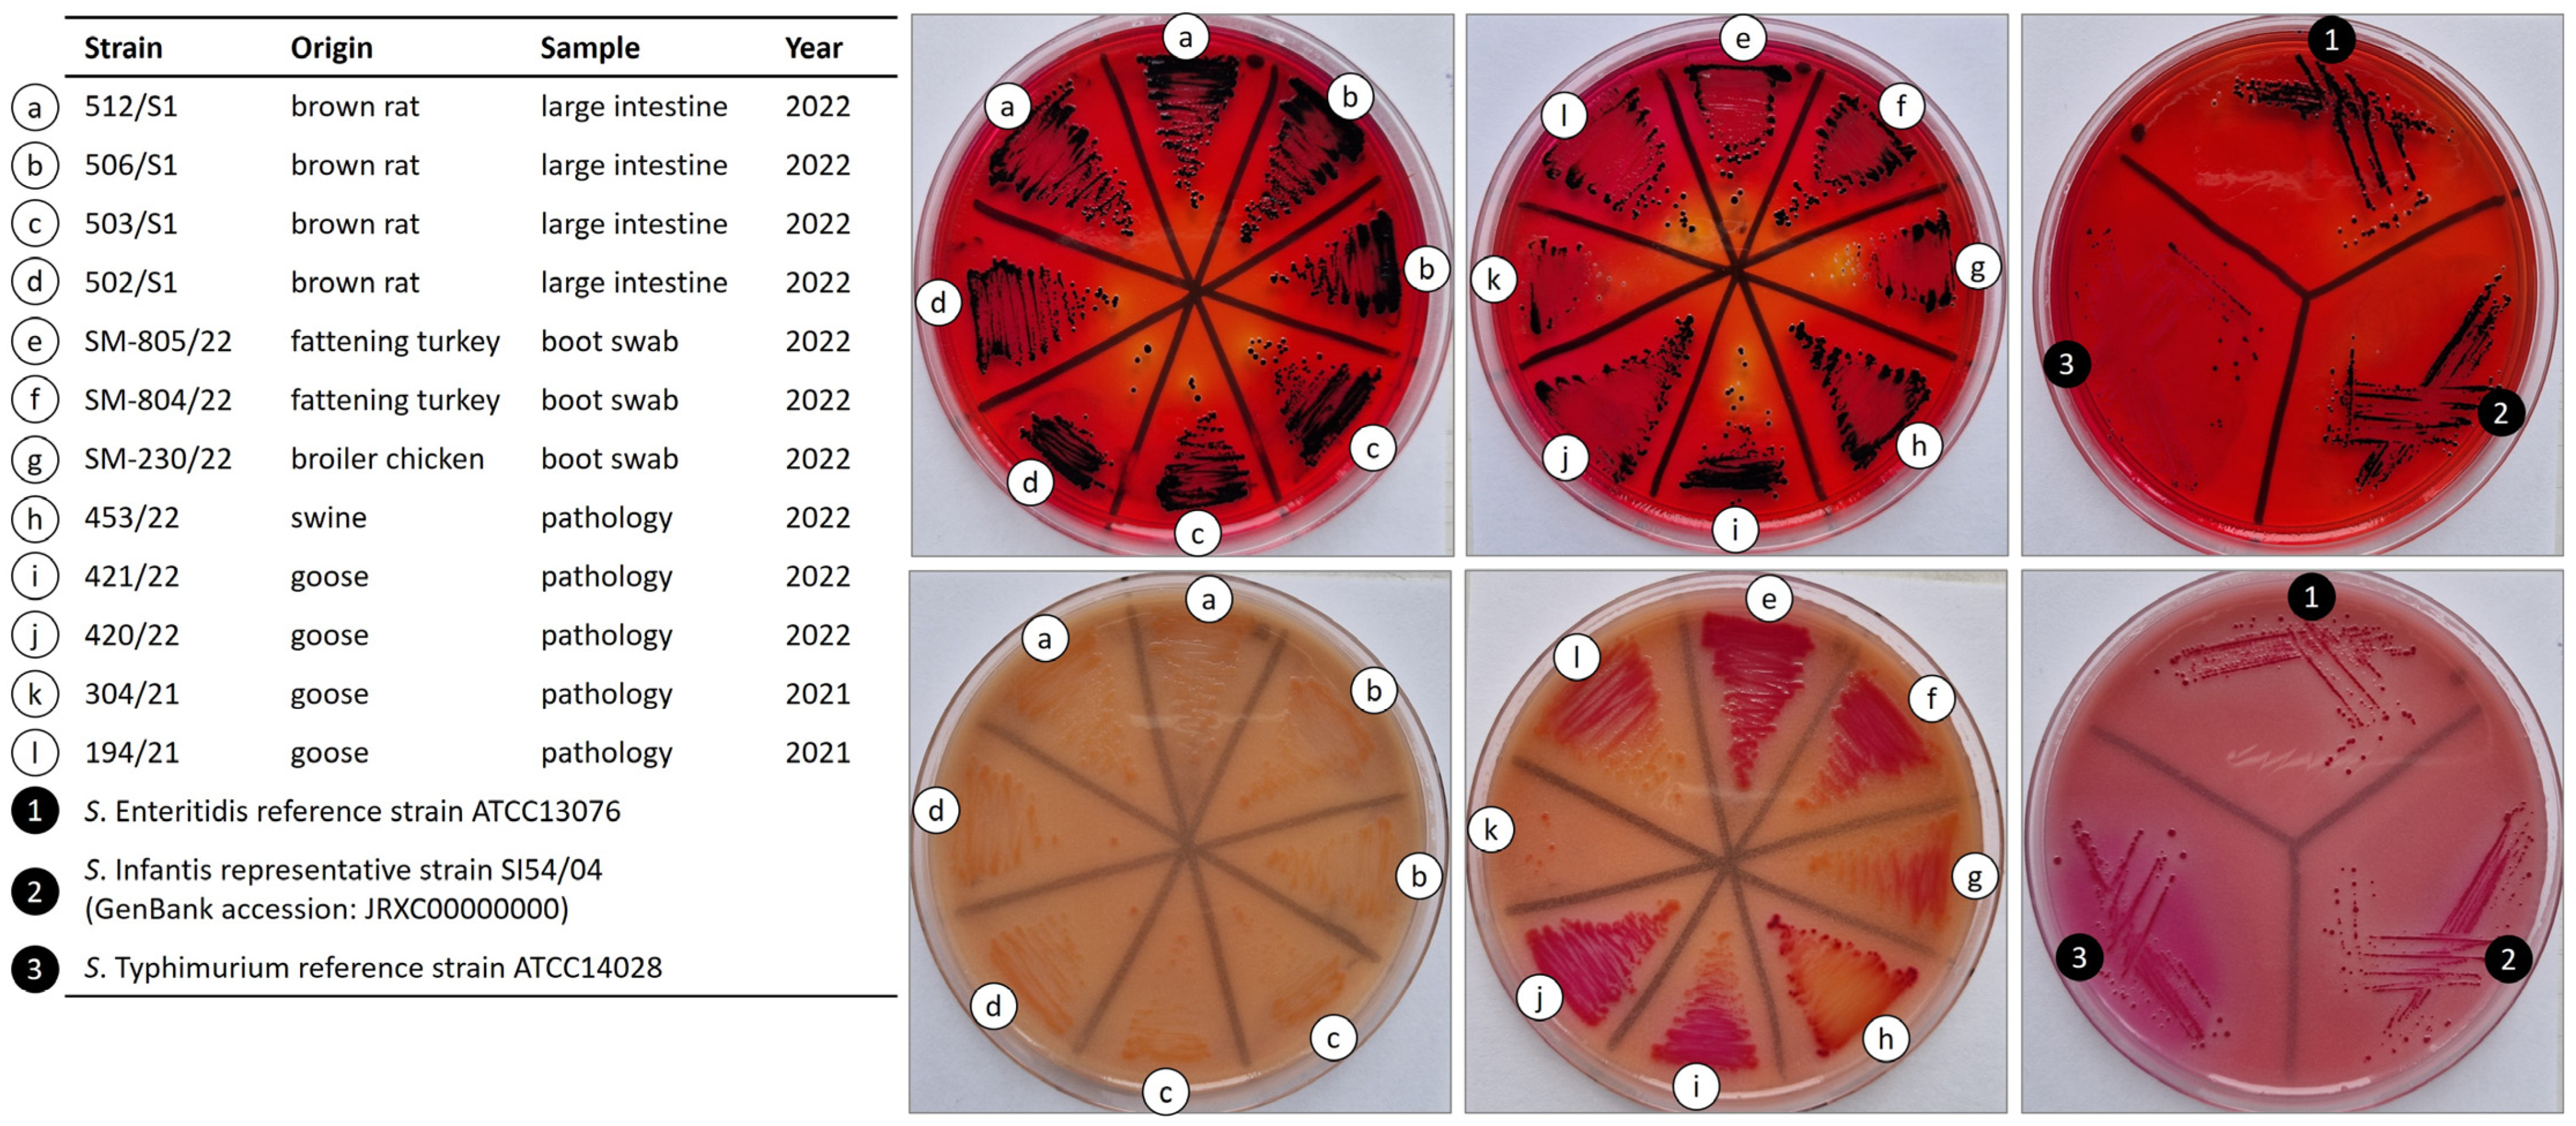
Ijms 25 08820 g001

Emergence and Comparative Genome Analysis of Salmonella Ohio Strains from Brown Rats, Poultry, and Swine in Hungary
Abstract
1. Introduction
2. Results
2.1. Prevalence and Distribution of S. Ohio Strains in Brown Rats and Food-Producing Animals
2.2. Phenotypic Features of S. Ohio Strains from Hungary
2.3. Comparison of the Genomic Determinants of Virulence and Antimicrobial Resistance
2.4. Phylogenetic Relation of S. Ohio Strains with Different Geographical Distributions
3. Discussion
4. Materials and Methods
4.1. Samples Collected from Brown Rats
4.2. Sample Processing, Detection, and Identification of Salmonella Strains
4.3. Antibiotic Susceptibility Testing of Salmonella Ohio Strains and Selection for Genome Analysis
4.4. Whole-Genome Sequencing and Prediction of the Antibiotic Resistance and Virulence Genotypes
4.5. Phylogenetic Analysis: MLST and Core Genome MLST
5. Conclusions
Supplementary Materials
Author Contributions
Funding
Institutional Review Board Statement
Informed Consent Statement
Data Availability Statement
Acknowledgments
Conflicts of Interest
References
- EFSA (European Food Safety Authority); ECDC (European Centre for Disease Prevention and Control). The European Union. One Health 2022 Zoonoses Report. EFSA J. 2023, 21, e8442. [Google Scholar] [CrossRef]
- Wang, M.; Qazi, I.H.; Wang, L.; Zhou, G.; Han, H. Salmonella Virulence and Immune Escape. Microorganisms 2020, 8, 407. [Google Scholar] [CrossRef] [PubMed]
- Lin, D.; Yan, M.; Lin, S.; Chen, S. Increasing Prevalence of Hydrogen Sulfide Negative Salmonella in Retail Meats. Food Microbiol. 2014, 43, 1–4. [Google Scholar] [CrossRef] [PubMed]
- Müştak, İ.B.; Müştak, H.K.; Sarıçam, S. Molecular Characterisation of Hydrogen Sulfide Negative Salmonella enterica Serovar Havana. Antonie Leeuwenhoek 2020, 113, 1241–1246. [Google Scholar] [CrossRef] [PubMed]
- Guiney, D.G.; Fierer, J. The Role of the Spv Genes in Salmonella Pathogenesis. Front. Microbiol. 2011, 2, 129. [Google Scholar] [CrossRef] [PubMed]
- Kang, L.; You, J.; Li, Y.; Huang, R.; Wu, S. Effects and Mechanisms of Salmonella Plasmid Virulence Gene Spv on Host-Regulated Cell Death. Curr. Microbiol. 2024, 81, 86. [Google Scholar] [CrossRef] [PubMed]
- Aviv, G.; Tsyba, K.; Steck, N.; Salmon-Divon, M.; Cornelius, A.; Rahav, G.; Grassl, G.A.; Gal-Mor, O. A Unique Megaplasmid Contributes to Stress Tolerance and Pathogenicity of an Emergent Salmonella enterica Serovar Infantis Strain. Environ. Microbiol. 2014, 16, 977–994. [Google Scholar] [CrossRef] [PubMed]
- Hindermann, D.; Gopinath, G.; Chase, H.; Negrete, F.; Althaus, D.; Zurfluh, K.; Tall, B.D.; Stephan, R.; Nüesch-Inderbinen, M. Salmonella enterica Serovar Infantis from Food and Human Infections, Switzerland, 2010–2015: Poultry-Related Multidrug Resistant Clones and an Emerging ESBL Producing Clonal Lineage. Front. Microbiol. 2017, 8, 1322. [Google Scholar] [CrossRef] [PubMed]
- Szmolka, A.; Szabó, M.; Kiss, J.; Pászti, J.; Adrián, E.; Olasz, F.; Nagy, B. Molecular Epidemiology of the Endemic Multiresistance Plasmid pSI54/04 of Salmonella Infantis in Broiler and Human Population in Hungary. Food Microbiol. 2018, 71, 25–31. [Google Scholar] [CrossRef] [PubMed]
- Bogomazova, A.N.; Gordeeva, V.D.; Krylova, E.V.; Soltynskaya, I.V.; Davydova, E.E.; Ivanova, O.E.; Komarov, A.A. Mega-Plasmid Found Worldwide Confers Multiple Antimicrobial Resistance in Salmonella Infantis of Broiler Origin in Russia. Int. J. Food Microbiol. 2019, 319, 108497. [Google Scholar] [CrossRef] [PubMed]
- Alikhan, N.-F.; Zhou, Z.; Sergeant, M.J.; Achtman, M. A Genomic Overview of the Population Structure of Salmonella. PLoS Genet. 2018, 14, e1007261. [Google Scholar] [CrossRef]
- Camba, S.I.; Valle, F.P.D.; Umali, D.V.; Soma, T.; Shirota, K.; Katoh, H.; Sasai, K. The Expanded Role of Roof-Rats (Rattus rattus) in Salmonella Spp. Contamination of a Commercial Layer Farm in East. Japan. Avian Dis. 2019, 64, 46–52. [Google Scholar] [CrossRef]
- Badger-Emeka, L.; Al-Mulhim, Y.; Al-Muyidi, F.; Busuhail, M.; Alkhalifah, S.; AlEid, N. An Investigation of Potential Health Risks from Zoonotic Bacterial Pathogens Associated with Farm Rats. Environ. Health Insights 2020, 14, 1178630220942240. [Google Scholar] [CrossRef]
- Dominguez, J.E.; Rosario, L.; Juliana, S.; Redondo, L.M.; Chacana, P.A.; Regino, C.; Miyakawa, M.E.F. Rats as Sources of Multidrug-resistant Enterobacteriaceae in Animal Production Environments. Zoonoses Public Health 2023, 70, 627–635. [Google Scholar] [CrossRef]
- Uea-Anuwong, T.; Byers, K.A.; Wahl, L.C.; Nekouei, O.; Grohn, Y.T.; Magouras, I. Antimicrobial Resistance in Bacteria Isolated from Peridomestic Rattus Species: A Scoping Literature Review. One Health 2023, 16, 100522. [Google Scholar] [CrossRef] [PubMed]
- Himsworth, C.G.; Zabek, E.; Desruisseau, A.; Parmley, E.J.; Reid-Smith, R.; Jardine, C.M.; Tang, P.; Patrick, D.M. Prevalence and characteristics of Escherichia coli and Salmonella spp. in the feces of wild urban norway and black rats (Rattus norvegicus and Rattus rattus) from an inners city neighborhood of Vancouver, Canada7. J. Wildl. Dis. 2015, 51, 589–600. [Google Scholar] [CrossRef]
- de Cock, M.P.; de Vries, A.; Fonville, M.; Esser, H.J.; Mehl, C.; Ulrich, R.G.; Joeres, M.; Hoffmann, D.; Eisenberg, T.; Schmidt, K.; et al. Increased Rat-Borne Zoonotic Disease Hazard in Greener Urban Areas. Sci. Total Environ. 2023, 896, 165069. [Google Scholar] [CrossRef]
- Sobrinho, C.P.; Godoi, J.L.; Souza, F.N.; Zeppelini, C.G.; Santo, V.E.; Santiago, D.C.; Alves, R.S.; Khalil, H.; Pereira, T.C.; Pinna, M.H.; et al. Prevalence of Diarrheagenic Escherichia coli (DEC) and Salmonella Spp. with Zoonotic Potential in Urban Rats in Salvador, Brazil. Epidemiol. Infect. 2020, 149, e128. [Google Scholar] [CrossRef] [PubMed]
- Ribas, A.; Saijuntha, W.; Agatsuma, T.; Prantlová, V.; Poonlaphdecha, S. Rodents as a Source of Salmonella Contamination in Wet Markets in Thailand. Vector-Borne Zoonotic Dis. 2016, 16, 537–540. [Google Scholar] [CrossRef]
- Velazquez, E.M.; Nguyen, H.; Heasley, K.T.; Saechao, C.H.; Gil, L.M.; Rogers, A.W.L.; Miller, B.M.; Rolston, M.R.; Lopez, C.A.; Litvak, Y.; et al. Endogenous Enterobacteriaceae Underlie Variation in Susceptibility to Salmonella Infection. Nat. Microbiol. 2019, 4, 1057–1064. [Google Scholar] [CrossRef] [PubMed]
- Zhang, J.; Teh, M.; Kim, J.; Eva, M.M.; Cayrol, R.; Meade, R.; Nijnik, A.; Montagutelli, X.; Malo, D.; Jaubert, J. A Loss-of-Function Mutation in the Integrin Alpha L (Itgal) Gene Contributes to Susceptibility to Salmonella enterica Serovar Typhimurium Infection in Collaborative Cross Strain CC042. Infect. Immun. 2019, 88, e00656-19. [Google Scholar] [CrossRef] [PubMed]
- Stevens, M.P.; Kingsley, R.A. Salmonella Pathogenesis and Host-Adaptation in Farmed Animals. Curr. Opin. Microbiol. 2021, 63, 52–58. [Google Scholar] [CrossRef] [PubMed]
- Falay, D.; Hardy, L.; Tanzito, J.; Lunguya, O.; Bonebe, E.; Peeters, M.; Mattheus, W.; Geet, C.V.; Verheyen, E.; Akaibe, D.; et al. Urban Rats as Carriers of Invasive Salmonella Typhimurium Sequence Type 313, Kisangani, Democratic Republic of Congo. PLoS Negl. Trop. Dis. 2022, 16, e0010740. [Google Scholar] [CrossRef] [PubMed]
- Ramatla, T.; Mileng, K.; Ndou, R.; Mphuti, N.; Syakalima, M.; Lekota, K.E.; Thekisoe, O.M.M. Molecular Detection of Integrons, Colistin and β-Lactamase Resistant Genes in Salmonella enterica Serovars Enteritidis and Typhimurium Isolated from Chickens and Rats Inhabiting Poultry Farms. Microorganisms 2022, 10, 313. [Google Scholar] [CrossRef] [PubMed]
- EFSA (European Food Safety Authority); ECDC (European Centre for Disease Prevention and Control). The European Union One Health 2021 Zoonoses Report. EFSA J. 2022, 20, e07666. [Google Scholar] [CrossRef]
- Sevilla-Navarro, S.; Catalá-Gregori, P.; Marin, C. Salmonella Bacteriophage Diversity According to Most Prevalent Salmonella Serovars in Layer and Broiler Poultry Farms from Eastern Spain. Animals 2020, 10, 1456. [Google Scholar] [CrossRef] [PubMed]
- Sanchez-Maldonado, A.F.; Aslam, M.; Service, C.; Narváez-Bravo, C.; Avery, B.P.; Johnson, R.; Jones, T.H. Prevalence and Antimicrobial Resistance of Salmonella Isolated from Two Pork Processing Plants in Alberta, Canada. Int. J. Food Microbiol. 2017, 241, 49–59. [Google Scholar] [CrossRef] [PubMed]
- Shigemura, H.; Maeda, T.; Nakayama, S.; Ohishi, A.; Carle, Y.; Ookuma, E.; Etoh, Y.; Hirai, S.; Matsui, M.; Kimura, H.; et al. Transmission of Extended-Spectrum Cephalosporin-Resistant Salmonella Harboring a blaCMY-2-Carrying IncA/C2 Plasmid Chromosomally Integrated by ISEcp1 or IS26 in Layer Breeding Chains in Japan. J. Vet. Méd. Sci. 2021, 83, 1345–1355. [Google Scholar] [CrossRef] [PubMed]
- Willson, N.-L.; Chousalkar, K. Dominant Salmonella Serovars in Australian Broiler Breeder Flocks and Hatcheries: A Longitudinal Study. Appl. Environ. Microbiol. 2023, 89, e0062723. [Google Scholar] [CrossRef] [PubMed]
- Ballesteros-Nova, N.E.; Sánchez, S.; Steffani, J.L.; Sierra, L.C.; Chen, Z.; Ruíz-López, F.A.; Bell, R.L.; Reed, E.A.; Balkey, M.; Rubio-Lozano, M.S.; et al. Genomic Epidemiology of Salmonella enterica Circulating in Surface Waters Used in Agriculture and Aquaculture in Central Mexico. Appl. Environ. Microbiol. 2022, 88, e0214921. [Google Scholar] [CrossRef] [PubMed]
- Rojas-Sánchez, E.; Jiménez-Soto, M.; Barquero-Calvo, E.; Duarte-Martínez, F.; Mollenkopf, D.F.; Wittum, T.E.; Muñoz-Vargas, L. Prevalence Estimation, Antimicrobial Susceptibility, and Serotyping of Salmonella enterica Recovered from New World Non-Human Primates (Platyrrhini), Feed, and Environmental Surfaces from Wildlife Centers in Costa Rica. Antibiotics 2023, 12, 844. [Google Scholar] [CrossRef] [PubMed]
- Joseph, P.G.; Yee, H.T.; Sivanandan, S.P. The Occurrence of Salmonellae in House Shrews and Rats in Ipoh, Malaysia. Southeast Asian J. Trop. Med. Public Health 1984, 15, 326–330. [Google Scholar]
- Kato, H.; Ueda, A.; Tsukiji, J.; Sano, K.; Yamada, M.; Ishigatsubo, Y. Salmonella enterica Serovar Ohio Septic Arthritis and Bone Abscess in an Immunocompetent Patient: A Case Report. J. Méd. Case Rep. 2012, 6, 204. [Google Scholar] [CrossRef]
- Godínez-Oviedo, A.; Tamplin, M.L.; Bowman, J.P.; Hernández-Iturriaga, M. Salmonella enterica in Mexico 2000–2017: Epidemiology, Antimicrobial Resistance, and Prevalence in Food. Foodborne Pathog. Dis. 2020, 17, 98–118. [Google Scholar] [CrossRef] [PubMed]
- Gruenewald, R.; Henderson, R.W.; Yappow, S. Use of Rambach Propylene Glycol Containing Agar for Identification of Salmonella spp. J. Clin. Microbiol. 1991, 29, 2354–2356. [Google Scholar] [CrossRef] [PubMed]
- Walter, D.; Ailion, M.; Roth, J. Genetic Characterization of the Pdu Operon: Use of 1,2-Propanediol in Salmonella Typhimurium. J. Bacteriol. 1997, 179, 1013–1022. [Google Scholar] [CrossRef] [PubMed]
- Burgueño-Roman, A.; Castañeda-Ruelas, G.M.; Pacheco-Arjona, R.; Jimenez-Edeza, M. Pathogenic Potential of Non-Typhoidal Salmonella Serovars Isolated from Aquatic Environments in Mexico. Genes Genom. 2019, 41, 767–779. [Google Scholar] [CrossRef] [PubMed]
- Gupta, S.K.; Sharma, P.; McMillan, E.A.; Jackson, C.R.; Hiott, L.M.; Woodley, T.; Humayoun, S.B.; Barrett, J.B.; Frye, J.G.; McClelland, M. Genomic Comparison of Diverse Salmonella Serovars Isolated from Swine. PLoS ONE 2019, 14, e0224518. [Google Scholar] [CrossRef] [PubMed]
- Dhanani, A.S.; Block, G.; Dewar, K.; Forgetta, V.; Topp, E.; Beiko, R.G.; Diarra, M.S. Genomic Comparison of Non-Typhoidal Salmonella enterica Serovars Typhimurium, Enteritidis, Heidelberg, Hadar and Kentucky Isolates from Broiler Chickens. PLoS ONE 2015, 10, e0128773. [Google Scholar] [CrossRef] [PubMed]
- Aviv, G.; Cornelius, A.; Davidovich, M.; Cohen, H.; Suwandi, A.; Galeev, A.; Steck, N.; Azriel, S.; Rokney, A.; Valinsky, L.; et al. Differences in the Expression of SPI-1 Genes Pathogenicity and Epidemiology between the Emerging Salmonella enterica Serovar Infantis and the Model Salmonella enterica Serovar Typhimurium. J. Infect. Dis. 2019, 220, 1071–1081. [Google Scholar] [CrossRef] [PubMed]
- Pong, C.H.; Hall, R.M. An X1α Plasmid from a Salmonella enterica Serovar Ohio Isolate Carrying a Novel IS26-Bounded Tet(C) Pseudo-Compound Transposon. Plasmid 2021, 114, 102561. [Google Scholar] [CrossRef] [PubMed]
- Leeper, M.M.; Tolar, B.M.; Griswold, T.; Vidyaprakash, E.; Hise, K.B.; Williams, G.M.; Im, S.B.; Chen, J.C.; Pouseele, H.; Carleton, H.A. Evaluation of Whole and Core Genome Multilocus Sequence Typing Allele Schemes for Salmonella enterica Outbreak Detection in a National Surveillance Network, PulseNet USA. Front. Microbiol. 2023, 14, 1254777. [Google Scholar] [CrossRef] [PubMed]
- Szmolka, A.; Wami, H.; Dobrindt, U. Comparative Genomics of Emerging Lineages and Mobile Resistomes of Contemporary Broiler Strains of Salmonella Infantis and E. coli. Front. Microbiol. 2021, 12, 642125. [Google Scholar] [CrossRef] [PubMed]
- ISO 6579-1:2017; Microbiology of the Food Chain—Horizontal Method for the Detection, Enumeration and Serotyping of Salmonella—Part 1: Detection of Salmonella spp. International Organization for Standardization: Geneva, Switzerland, 2017.
- Aabo, S.; Rasmussen, O.F.; Roseen, L.; Sørensen, P.D.; Olsen, J.E. Salmonella identification by the polymerase chain reaction. Mol. Cell. Probes 1993, 7, 171–178. [Google Scholar] [CrossRef] [PubMed]
- ISO/TR 6579-3:2014; Microbiology of the Food Chain—Horizontal Method for the Detection, Enumeration and Serotyping of Salmonella—Part 3: Guidelines for Serotyping of Salmonella spp. International Organization for Standardization: Geneva, Switzerland, 2014.
- The European Committee on Antimicrobial Susceptibility Testing (EUCAST). Breakpoint Tables for Interpretation of MICs and Zone Diameters, Version 8.0; The European Committee on Antimicrobial Susceptibility Testing (EUCAST): Växjö, Sweden, 2018. [Google Scholar]
- Andrews, S. FastQC: A Quality Control Tool for High Throughput Sequence Data. 2010. Available online: http://www.bioinformatics.babraham.ac.uk/projects/fastqc (accessed on 17 November 2023).
- Bankevich, A.; Nurk, S.; Antipov, D.; Gurevich, A.A.; Dvorkin, M.; Kulikov, A.S.; Lesin, V.M.; Nikolenko, S.I.; Pham, S.; Prjibelski, A.D.; et al. SPAdes: A New Genome Assembly Algorithm and Its Applications to Single-Cell Sequencing. J. Comput. Biol. 2012, 19, 455–477. [Google Scholar] [CrossRef] [PubMed]
- Zhang, S.; Yin, Y.; Jones, M.B.; Zhang, Z.; Kaiser, B.L.D.; Dinsmore, B.A.; Fitzgerald, C.; Fields, P.I.; Deng, X. Salmonella Serotype Determination Utilizing High-Throughput Genome Sequencing Data. J. Clin. Microbiol. 2015, 53, 1685–1692. [Google Scholar] [CrossRef] [PubMed]
- Jünemann, S.; Sedlazeck, F.J.; Prior, K.; Albersmeier, A.; John, U.; Kalinowski, J.; Mellmann, A.; Goesmann, A.; Haeseler, A.; von Stoye, J.; et al. Updating benchtop sequencing performance comparison. Nat. Biotechnol. 2013, 31, 294–296. [Google Scholar] [CrossRef]
- Achtman, M.; Wain, J.; Weill, F.-X.; Nair, S.; Zhou, Z.; Sangal, V.; Krauland, M.G.; Hale, J.L.; Harbottle, H.; Uesbeck, A.; et al. Multilocus Sequence Typing as a Replacement for Serotyping in Salmonella enterica. PLoS Pathog. 2012, 8, e1002776. [Google Scholar] [CrossRef] [PubMed]

| Animal/Source | Total Tested | Prevalence (n) | Strains |
|---|---|---|---|
| Brown rat | n = 92 | 4.3% (4) | 502/S1; 503/S1; 506/S1; 512/S1 * |
| Broiler chicken (2022) a | n = 17,134 | 6‰ (1) | SM-230/22 * |
| Fattening turkey (2022) a | n = 3593 | 0.056% (2) | SM-804/22 *; SM-805/22 |
| Goose (2021) b | n = 3593 | 0.056% (2) | 194/21 *; 304/21; |
| Goose (2022) b | n = 130 | 1.5% (2) | 420/22; 421/22 |
| Swine (2022) b | n = 48 | 2.0% (1) | 453/22 * |
Disclaimer/Publisher’s Note: The statements, opinions and data contained in all publications are solely those of the individual author(s) and contributor(s) and not of MDPI and/or the editor(s). MDPI and/or the editor(s) disclaim responsibility for any injury to people or property resulting from any ideas, methods, instructions or products referred to in the content. |
© 2024 by the authors. Licensee MDPI, Basel, Switzerland. This article is an open access article distributed under the terms and conditions of the Creative Commons Attribution (CC BY) license (https://creativecommons.org/licenses/by/4.0/).
Share and Cite
Szmolka, A.; Lancz, Z.S.; Rapcsák, F.; Egyed, L. Emergence and Comparative Genome Analysis of Salmonella Ohio Strains from Brown Rats, Poultry, and Swine in Hungary. Int. J. Mol. Sci. 2024, 25, 8820. https://doi.org/10.3390/ijms25168820
Szmolka A, Lancz ZS, Rapcsák F, Egyed L. Emergence and Comparative Genome Analysis of Salmonella Ohio Strains from Brown Rats, Poultry, and Swine in Hungary. International Journal of Molecular Sciences. 2024; 25(16):8820. https://doi.org/10.3390/ijms25168820
Chicago/Turabian StyleSzmolka, Ama, Zsuzsanna Sréterné Lancz, Fanni Rapcsák, and László Egyed. 2024. "Emergence and Comparative Genome Analysis of Salmonella Ohio Strains from Brown Rats, Poultry, and Swine in Hungary" International Journal of Molecular Sciences 25, no. 16: 8820. https://doi.org/10.3390/ijms25168820
APA StyleSzmolka, A., Lancz, Z. S., Rapcsák, F., & Egyed, L. (2024). Emergence and Comparative Genome Analysis of Salmonella Ohio Strains from Brown Rats, Poultry, and Swine in Hungary. International Journal of Molecular Sciences, 25(16), 8820. https://doi.org/10.3390/ijms25168820

